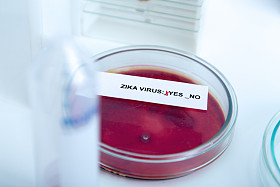
积极与 Zika 病毒的血液样本

Zika 病毒蚕种
图片基本信息
图片ID:40463
图片大小:4.67MB
图片尺寸:3888 x 2592 像素
颜色模式:RGB
文件格式:JPG
推荐软件:PS,AI
用途:医疗健康
构图:横图
版权说明:如需购买商用授权,请购买企业VIP
授权对象:企业,个人
图司机为设计师提供高清Zika 病毒蚕种图片版权下载,图片为医疗健康,大小为4.67MB,尺寸为3888 x 2592px,更多关于背景,健康,危险,鲜血,小小,医学,病症,医疗,关心...,哭了,昆虫科,发烧,发烧,医院,叮咬,疾病,生物学,宝贝,病毒,研究,生病,害虫,诊断,寄生虫,巴西,蚊子,流行,感染,疟疾,蚕种,白纹伊蚊,登革热,埃及伊蚊,宝宝哭泣,小脑积水,zika,microcefalia商用高清版权图片,快来图司机免费下载吧。